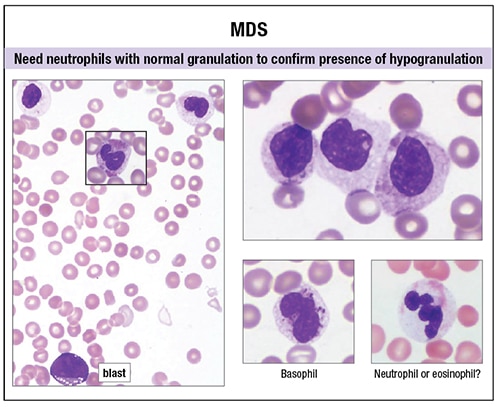

Amy Carpenter Aquino
March 2019—Unlike high-count monoclonal B-cell lymphocytosis, low-count MBL has a limited chance of progression to CLL and thus there is no need for follow-up. And a definitive diagnosis of T-cell large granulocytic leukemia requires demonstration of clonality. Those and other points were made in a CAP18 session on practical challenges in peripheral blood evaluation.
Carla S. Wilson, MD, PhD, professor of hematopathology, and Devon S. Chabot-Richards, MD, associate professor of hematopathology and molecular pathology, Department of Pathology, University of New Mexico School of Medicine, presented seven of their cases illustrating the challenges of peripheral blood smear evaluation, three of which are reported on here (with others to be published in April). Drs. Wilson and Chabot-Richards are medical directors at TriCore Reference Laboratories, Albuquerque.

morphology is not good enough.’ —Carla Wilson, MD, PhD
The key to an accurate peripheral blood examination is a good-quality peripheral blood smear with different zones that can be evaluated, Dr. Wilson said. “The lateral edges are where large cells such as monocytes, immunoblasts, immature cells, and blasts are often deposited.” The feathered edge of the blood smear is where platelet clumps will be seen, as will sometimes malignant cell clumps and microorganisms. “You should not be doing your differential diagnosis at the feathered edge; the morphology is not good enough,” Dr. Wilson said. Instead, do your differential counts and observe morphology in the monolayer or thin area, where the cells are nicely separated. “A systematic approach is best where you scan at low power to look at the overall number of cells and types of cells and then go to high power for assessment of red cell, white cell, and then platelet appearance,” she said.
[dropcap]T[/dropcap]he first case is that of a peripheral blood smear Dr. Wilson examined on a 58-year-old woman with no significant medical history who visited her physician eight months after a health fair screening that found an elevated white blood cell count with increased lymphocytes.
“We found on her CBC that she had a mild leukocytosis due to a lymphocytosis,” Dr. Wilson said. “The rest of the counts were normal.” The lymphocytes were 40 percent of WBCs, with an absolute lymphocyte count of 4.4 × 109/L.
Dr. Wilson described normal lymphocytes as small, with round or oval nuclei, condensed chromatin, and scant, blue, and agranular cytoplasm.
A lymphocytosis can be reactive (non-neoplastic) or neoplastic (Fig. 1). Non-neoplastic types have more variability in cell sizes and shapes, and more pleomorphism, than what one usually sees in neoplastic processes, which tend to be more uniform, Dr. Wilson said. “But there are exceptions.”
Non-neoplastic lymphocytosis can be further divided into nonactivated and activated types.

“An important cause for nonactivated lymphocytosis that needs to be recognized nowadays is Bordetella pertussis or whooping cough,” which is increasing because of under-vaccination in many communities, Dr. Wilson said. A significant fraction of small lymphocytes with cleaved or convoluted nuclei and scant cytoplasm provides a clue to identification of this disorder.
Another clue: Infants and young children present with very high WBC counts. “The pertussis toxin decreases the L-selectin on the surface of T-lymphocytes, so they don’t migrate through vessels into tissue. The lymphocytes build up within the vessels and become a lymphocytosis.”
The disorder is trickier to spot in adults, she noted, because two-thirds of adults will have normal WBC and lymphocyte counts by the time they seek medical attention.
In non-neoplastic lymphocytosis with activated lymphocytes, the lymphocytes tend to be much more variable in appearance with a greater number of large cells. Downey type II lymphocytes are intermediate to large cells with smudged chromatin, inconspicuous nuclei, and abundant pale blue cytoplasm with a rim of basophilia, which are associated with viral infections, particularly infectious mononucleosis from Epstein-Barr virus infection. “If you have a lymphocytosis in a 15- to 24-year-old in the U.S., with activated lymphocytes, make sure you exclude EBV-associated infectious mononucleosis, even if the heterophile antibody [monospot] test is negative. Continue evaluating with EBV-specific antibody testing,” Dr. Wilson advises.
In neoplastic lymphocytosis, B-cell neoplasms are much more common than T- or NK-cell neoplasms. The differential for B-cell neoplasms depends on the patient’s age, clinical symptoms, morphologic appearance, and physical exam. “Look for laboratory findings, such as paraproteins or cytopenias,” she said. Composite findings will help determine which cases should be evaluated by flow cytometry and other ancillary testing.

—Devon Chabot-Richards, MD
When a case is evaluated by flow cytometry, it is important to correlate the morphology with the immunophenotype. “Mature B-cell populations are clonal by flow cytometry when light chain restriction or loss of light chain expression is identified, which is the first thing to look for,” Dr. Wilson said.
The second most useful marker to evaluate for mature B-cell neoplasms with small to midsize lymphoid cells is CD5. Chronic lymphocytic leukemia (CLL) is the most common B-cell lymphoproliferative disorder and is CD5 positive. The main differential diagnosis is mantle cell lymphoma (MCL). Sometimes the latter resembles CLL, which requires evaluating the rest of the immunophenotype. CLL typically has dimmer CD20 and light chain expression than MCL, and is CD23 positive and FMC7 negative, while MCL is most commonly FMC7 positive and CD23 negative.
“We like CD200 as our new marker,” since CD200 is brightly positive in CLL but not in the majority of MCL cases, she said.
If there is any hint that the morphology or immunophenotype is not characteristic, Dr. Wilson said her laboratory performs FISH for t(11;14)(q13;q32) to identify MCL. “If it is CLL, we do FISH and IGHV mutation testing for prognosis.”
For cases that are CD5 negative, next consider whether CD10 is expressed. “The majority of CD10-positive B-cell neoplasms are follicular lymphoma in circulation. You often see small cleaved cells on peripheral smear review.” Hairy cell leukemia, she cautions, will be CD10 positive in 10 to 20 percent of cases. Hairy cell leukemia cells have more abundant cytoplasm with circumferential cytoplasmic projections, and oval or reniform nuclei. “Whether it is CD10 positive or not, hairy cell leukemias have very bright CD20 expression, which is a clue to perform markers for hairy cell leukemia.”
Cases that are CD5 and CD10 negative require additional testing once hairy cell leukemia is excluded as they could be marginal zone lymphoma, lymphoplasmacytic lymphoma, rare splenic lymphomas, or possibly not even lymphoma. More than 90 percent of lymphoplasmacytic lymphomas are MYD88 L265P mutation positive and hairy cell leukemias BRAF V600E mutation positive, both of which can be interrogated in peripheral blood.
Flow cytometry had been performed on the peripheral blood of the 58-year-old patient (“debatable,” Dr. Wilson said of the need for flow, “but the clinician had already sent it”), which revealed a dim lambda-light chain restricted B-cell population that expressed dim CD20, CD5, CD23, and bright CD200, and comprised 32 percent of leukocytes. “While the immunophenotype is that of CLL, the diagnosis depends on the monoclonal B-cell count, which for our woman was 3.5 × 109/L” (WBC 11.0 × 109/L, × 32 percent). This does not meet the threshold of 5 × 109/L required for a diagnosis of CLL, and in the absence of lymphadenopathy, the woman was diagnosed as having a monoclonal B-cell lymphocytosis (MBL).

The 2016 revision of the WHO classification of lymphoid neoplasms, released in 2017, no longer permits a diagnosis of CLL based on associated cytopenias or disease-related symptoms, Dr. Wilson said. The 2016 WHO guidelines also call for distinguishing between high- and low-count MBL. Low-count MBL (less than 0.5 × 109/L monoclonal B-cells) has little to no risk for progression and does not require follow-up. Since the patient in this case has a high-count MBL (0.5–5.0 × 109/L monoclonal B-cells), she has a one to two percent per year risk of progressing to CLL. “This is considered biologically similar to CLL Rai 0 with an increased risk for infection and secondary cancer, and yearly follow-up by flow cytometric evaluation recommended to monitor for progression,” Dr. Wilson said.
The 2016 WHO guidelines further divided MBL into three types: CLL-type (the majority of MBL cases); atypical CLL-type, CD5 positive (need to exclude MCL); and non-CLL-type, CD5 negative. In patients who are non-CLL-type, CD5 negative, the recommendation is to rule out lymphoma with a CT scan or ultrasound, and perform bone marrow or lymph node evaluation if indicated.
“For CLL, a diagnosis based on peripheral blood findings and flow cytometry is sufficient,” Dr. Wilson said. Bone marrow examination is mainly required if the patient is being assessed for remission or is on a clinical trial. The adverse prognostic factors that need to be looked for, particularly in young patients, are immunoglobulin heavy chain variable region (IGHV) mutations (“About half the patients are nonmutated, which is bad,” she said), CD49d (“easily assessed by flow cytometry”), and del(17p) or TP53 mutation. TP53 is important to detect because those patients are often fludarabine refractory. Next-generation sequencing is identifying additional adverse mutations (i.e. NOTCH, SF3B1) that have therapeutic implications.
“The question for the future is, with so many of our new targeted molecular therapies, what will be the relevance of our current prognostic markers? Stay tuned for that.”
[dropcap]C[/dropcap]ase No. 2 is that of a 60-year-old woman with a long history of rheumatoid arthritis and recurrent bacterial infections. Her CBC showed mild anemia.
“We practice in Albuquerque, New Mexico, which is at high altitude, so our red blood cell parameters are actually a little higher than other places,” Dr. Chabot-Richards said.
The peripheral blood smear showed that neutrophils were slightly lower than usual, at 22 percent of white blood cells. Her lymphocytes were at 59 percent and appeared mature with nicely condensed chromatin. Monocytes were moderate and not concerning. The edge of the blood smear showed more mature lymphocytes with plenty of cytoplasm, with very granular cytoplasm visible at a higher power.

After discussion with the clinician, the case was sent out for flow cytometry. The patient had increased T-cells with co-expression of CD8, CD16, and CD57, with some loss of CD5. The abnormal flow finding and the clinical picture prompted molecular testing for T-cell gene rearrangement, which was positive for a clonal rearrangement. The oncologist further requested that the case be sent out for STAT3 mutation molecular testing, which was also positive.
The patient was diagnosed with T-cell large granulocytic leukemia (T-LGL), a persistent clonal proliferation of T-cell large granular lymphocytes that makes up two to three percent of chronic lymphoproliferative disorders. “It can be difficult to prove clonality in many T-cell disorders,” Dr. Chabot-Richards said.
T-LGL occurs most often in adults ages 45 to 75 and is commonly associated with autoimmune disorders, such as rheumatoid arthritis. The condition is likely due to chronic antigenic stimulation, she said. A benign proliferation of T-cells persists in the body and then develops mutations that lead to a clonal proliferation.
The recommended lymphocyte count at diagnosis is greater than 2 × 109/L, but T-LGL can be diagnosed at a lower percentage in the presence of clinical features or proof of a clonal process. Lymphocytes should also account for greater than 15 percent of the white blood cell count (normal is about five percent).

Patients commonly have neutropenia and may have anemia, but thrombocytopenia is rare. Bone marrow red blood cell hypoplasia is common, and patients often have mild to moderate splenomegaly.
“This is very difficult to diagnose,” Dr. Chabot-Richards said. “Our first ancillary test that helps us out is the flow immunophenotype. It’s a mature, post-thymic, T-cell phenotype” with CD3, CD57, CD16, and CD2. The vast majority of cases are CD8 positive and T-cell receptor α/β positive. They can also show loss of normal T-cell antigens, most commonly CD5 and CD7.
A STAT3 mutation is seen in 70 percent of cases of T-LGL (“not specific; it’s seen in many other disorders”), while another subset of cases has a STAT5B mutation, which is more commonly seen in CD4-positive cases. “This is an interesting finding because they are also coming out with STAT3 inhibitors, so this is a potential target for treatment,” Dr. Chabot-Richards said.
The majority of T-LGL cases have positive T-cell gene rearrangement, and testing is required to prove clonality. The normal distribution of the lengths of the T-cell receptor gene should have a nice bell curve. In clonal processes, there is usually a single dominant peak. “In 30 percent of cases, the length of this sequence will actually change over the course of the disease. So you can’t compare in the same patient and necessarily prove it’s the same process.”

Patients who have multiple waxing and waning clones are similar to patients who have a stable clone, so it does not predict their disease.
“T-LGL cases do have a heterogeneous course,” Dr. Chabot-Richards said. They are typically indolent, and about half the time patients are symptomatic at diagnosis while the other half are found incidentally on the CBC.
Some cases spontaneously regress, “so the thinking is, the process is driven by chronic antigen stimulation and chronic inflammation. If you can control what is causing that, you can help treat the leukemia,” she said.
Other cases progress and require treatment, and normal progression is that the patients would have increasing cytopenias and become symptomatic. “Patients can have recurrent infections due to immune dysregulation” and other immune system problems, she said.
The traditional chemotherapy for these patients, if needed, is methotrexate or cyclophosphamide. Clinical trials are underway for STAT3 inhibitors.
The differential diagnosis would be B-cell disorders, which Dr. Wilson discussed, and other T-cell disorders: Sezary syndrome (CD4 positive in majority of cases, versus CD8), T-cell prolymphocytic leukemia (rapidly rising, very high WBC count and CD4 positive or, in a subset, CD4/CD8 double positive), and adult T-cell leukemia (usually CD4 and CD25 positive, CD57 negative).
“The NK cell disorders can be a little difficult to pick apart sometimes,” Dr. Chabot-Richards said. They are CD2, CD16, and CD56 positive and should be surface CD3 negative. T-cell clonality studies should be negative. “Instead, you can look at KIR receptors to see if that has clonal restriction,” which is a send-out test and done in only a few laboratories.
Chronic lymphoproliferative disorders of NK cells have morphology that is indistinguishable from large granular lymphocytic leukemia (LGL). Immunophenotype is key to distinguishing these disorders from LGL. Patients with aggressive NK-cell leukemia, on the other hand, are easier to distinguish because they have acute symptoms and morphologic abnormalities.
“We also have to distinguish T-LGL from reactive granular lymphocyte expansions,” she said. “This can be very difficult because there is a lot of overlap.” Viral infections—most commonly Epstein-Barr virus and cytomegalovirus—will be associated with a T-cell lymphocytosis.
“The big question is, when do we run flow cytometry on our patients with a cytosis?” (Fig. 2). If there is anything that looks monomorphic on the peripheral blood smear, and certainly if there is anything with a CLL-like phenotype, it is important to consider flow cytometry. Age greater than 65 is a factor. And studies have shown that a good lymphocyte count to consider reflex flow cytometry is greater than 6.7 × 109/L, for a 95 percent sensitivity and 76 percent specificity for finding a neoplastic process.
[dropcap]C[/dropcap]ase No. 3 is that of a 47-year-old man with a history of medical problems including the following: a 1996 cadaveric renal transplant due to diabetes mellitus; lymph node diagnosed with an early post-transplant lymphoproliferative disorder in 2002; classic Hodgkin lymphoma diagnosed in 2003 and treated with five cycles of chemotherapy; and a second renal transplant in 2014 for end-stage renal disease owing to diabetes.
The patient was on a number of medications, among them Bactrim, mycophenolate mofetil, tacrolimus, and prednisone.
“I received a peripheral blood smear for review from the technologists who had questions about it,” Dr. Wilson said. The smear showed a mild, normochromic normocytic anemia with other lineages intact, and an increased number of abnormally segmented neutrophils. Abnormal neutrophil segmentation can be hyposegmented or hypersegmented. If it is hyposegmented, as in the smear reviewed, the two main considerations are a congenital or an acquired Pelger-Huët anomaly.
Congenital Pelger-Huët anomaly was first described in 1928 by Dr. Karl Pelger as a defect in neutrophil segmentation with neutrophils having short and compact nuclei containing very clumped chromatin. In 1931, Dr. G. J. Huët recognized this to be a benign, autosomal dominant, inherited disorder, which is now called Pelger-Huët anomaly. The cause was discovered in 2000 to be due to lamin B receptor (LBR) gene mutations.
The heterozygous form of Pelger-Huët anomaly affects nearly one in 5,000 people in the United States. The homozygous form is rarely seen because it is lethal in utero in most cases.
The LBR gene codes for LBR protein on the inner surface of the nuclear membrane. “This protein allows for trafficking of heterochromatin and nuclear lamins, which form the scaffolding proteins of the nuclear membrane,” Dr. Wilson said.
Mutations result in a decreased amount of this functional protein and decreased segmentation of nuclei.
In the congenital form of Pelger-Huët anomaly, the LBR protein amount determines the degree of segmentation (Fig. 3). Most cases (heterozygous) have bilobed nuclei that are symmetrical in appearance and are separated by thin chromatin strands, often described as resembling pince-nez glasses, or thicker strands shaped more like a dumbbell. Only a few cells, termed Stodtmeister cells, are monolobated with nuclei resembling peanuts or coffee beans. These cells are more frequently observed in acquired pseudo-Pelger-Huët anomaly. Chromatin is usually very clumped. The cytoplasm appears normal, so the cells function normally and patients usually do not have associated cytopenias.
Acquired pseudo-Pelger-Huët anomaly can be iatrogenic or secondary to a neoplastic disorder. Iatrogenic causes are most commonly associated with transplant medications, though a number of other drugs can be responsible, as well as infections and inflammatory disorders. About five percent of renal transplant patients receiving medications have transient pseudo-Pelger-Huët anomaly.
“Hypotheses for the pseudo-Pelger-Huët appearance to the neutrophils are that drugs, infection, or inflammation cause downregulation of LBR gene expression, or that they interact with the LBR proteins to downregulate protein function,” Dr. Wilson said.
A peripheral blood smear from a two-year-old with a severe bacterial infection showed a number of pseudo-Pelger-Huët-type nuclei with asymmetrical nuclear lobation and Stodtmeister cells (Fig. 4). “You could see the neutrophilic left shift with toxic granulation and reactive appearing monocytes in the background, so this was not a congenital Pelger-Huët anomaly.”
“When pseudo-Pelger-Huët anomaly is observed on a blood film, concern for a myelodysplastic syndrome [MDS] often arises,” she said. A study of patients with acquired pseudo-Pelger-Huët anomaly (Wang E, et al. Am J Clin Pathol. 2011;135[2]:291–303) found that on average, a greater proportion of neutrophils have pseudo-Pelger-Huët-type nuclei in the iatrogenic causes than with MDS. The neutrophil hyposegmentation also resolves with adjustments of medications or disease resolution.
To assist in diagnosing MDS (Fig. 5), “there are a number of findings we look for on peripheral blood smear review that we consider dysplastic,” Dr. Wilson said, although none is specific or pathognomonic. “You have to make sure that everything reactive is excluded that could cause similar changes.” Anemia is the most common cytopenia associated with MDS and is usually normochromic normocytic, or macrocytic, with some anisopoikilocytosis, and coarse basophilic stippling can be seen. “One of the easiest dysplastic changes to recognize in the peripheral blood is hypogranulation of the neutrophil cytoplasm,” for which she advises caution and a well-stained smear.
“In a patient with MDS (Fig. 6), neutrophils with normal appearing cytoplasmic granules should always be present on the same slide as hypogranular neutrophils to ensure adequacy of staining,” Dr. Wilson said. Pseudo-Pelger-Huët cells associated with MDS differ from congenital Pelger-Huët anomaly by their increased nuclear heterogeneity, increased N:C ratios, and less condensed chromatin.
The 2016 revision to the WHO classification of myeloid neoplasms revises the MDS categories. “The new classification uses a combination of the number of cytopenias, the number of cell lineages that have more than 10 percent dysplasia per lineage, and the percent blasts in peripheral blood and bone marrow to define seven major categories,” Dr. Wilson said. The WHO also recommends providing in reports the cytologic features described as being dysplastic. The requirement for MDS classification based on blasts has also changed. Previously, if there was one percent blasts in the peripheral blood, it was at least an MDS unclassifiable. “Now you have to repeat with a second blood smear at a different time to confirm the one percent blasts. Bone marrow testing is required additionally to assess for ring sideroblasts and to do cytogenetics, particularly to look for chromosome 5q deletions.”
Amy Carpenter Aquino is CAP TODAY senior editor.